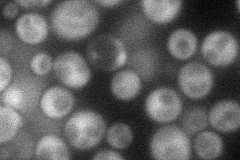
YBL054W
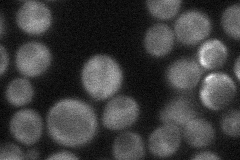
YBL054W
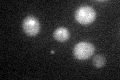
YBL054W

View description
PAC motif binding protein involved in rRNA and ribosome biogenesis; subunit of the RPD3L histone deacetylase complex; Myb-like HTH transcription factor, similar to Dot6p; hypophosphorylated by rapamycin treatment in a Sch9p-dependent manne
Localization:
Intensity:
Fold change:
Significance:
-
C’ GFP library in SD

below threshold16.23 -
N' NOP1pr-GFP in SD
cytosol66.794 -
N' TEF2pr-mCherry in SD

cytosol45.4741 -
N' NATIVEpr-GFP in SD
cytosol38.2279 -
N' TEF2pr-VC and Cyto-VN in SD

#N/A0 -
C’ GFP library in SD+DTT
cytosol16.871.03No -
C’ GFP library in SD+H2O2

cytosol14.820.91No -
C’ GFP library in Starvation Media

cytosol13.170.81No -
C’ GFP library on the background of Pup2-DaMP

below threshold -
C’ GFP library on the background of CCT mutant

below threshold17.62651.08512No
